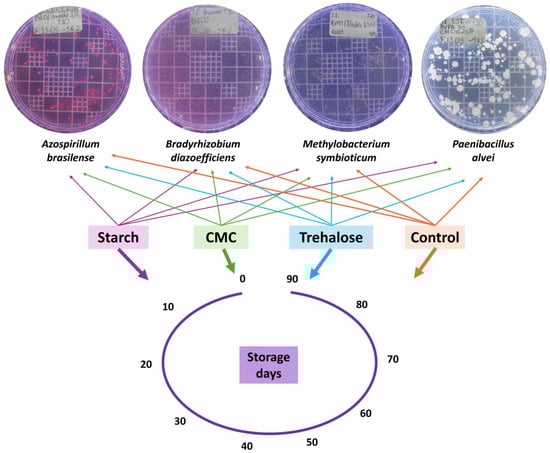

Abstract
The development of efficient bioinoculant formulations requires compounds with stabilizing, thickening, and carrier functions to preserve microbial viability and promote biological activity in soil. However, the majority of studies evaluate inoculant formulations predominantly in terms of bacterial viability, overlooking other important performance parameters. This study employed an integrative approach combining in vitro and plant-based assays to assess the effects of starch, carboxymethyl cellulose (CMC), and trehalose in formulations containing Azospirillum brasilense, Bradyrhizobium diazoefficiens, Methylobacterium symbioticum, and Paenibacillus alvei, applied to Glycine max seeds. Our hypothesis was that the presence of these additives, each with distinct functional roles (starch as a slow-release carbon source, CMC as a structural agent and protector against physical stress, and trehalose as an osmoprotectant and membrane stabilizer), would influence not only bacterial viability but also the seed germination, growth, and physiological responses of inoculated G. max plants. Starch improved viability in A. brasilense formulations, while both starch and trehalose had positive effects on M. symbioticum. These additives also enhanced plant traits, including dry biomass, chlorophyll content, carboxylation efficiency (A/Ci), and photochemical efficiency (Fv/Fm and Pi_Abs). Trehalose was particularly effective in formulations with B. diazoefficiens and M. symbioticum, supporting its use as a versatile stabilizer. In contrast, CMC (0.25%) negatively impacted bacterial viability, especially for B. diazoefficiens and P. alvei, and impaired physiological parameters in G. max when combined with M. symbioticum. These results highlight the need to evaluate formulation components not only for their physical roles but also for their specific interactions with microbial strains and effects on host plants. Such an integrative approach is essential for designing stable, efficient bioinoculants that align with sustainable agricultural practices.
1. Introduction
Plant growth-promoting rhizobacteria (PGPRs) enhance crop productivity through multiple mechanisms, including nitrogen fixation, the solubilization of soil phosphorus and potassium, and the production of siderophores and phytohormones [1,2,3,4]. Additionally, interactions between host plants and their associated microorganisms are critical for plant health, influencing development across various phenological stages [5,6,7]. It is well established that plants acquire defense and tolerance mechanisms against both biotic (e.g., pathogens and pests) and abiotic (e.g., drought and nutrient deficiency) stresses through symbiotic relationships with microorganisms [8,9].
Given this context, a major challenge for the scientific community and the bioinoculant, biofertilizer, and biocontrol industries is to develop technologies that enable the efficient and reliable application of microbial agents in agriculture. Effective PGPR formulations can enhance soil fertility, increase crop resilience, boost productivity, and support nutrient cycling in agroecosystems [10,11]. Research efforts should therefore prioritize not only the isolation of novel strains but also the development of robust formulations suitable for diverse environmental conditions.
A primary limitation in bioinoculant formulation lies in maintaining microbial viability during storage and ensuring biological activity upon soil application [12]. Microbial inoculants are often vulnerable to extended storage periods and adverse environmental conditions, which can compromise their viability and reduce field performance [13]. This issue is especially pronounced in non-sporulating bacteria, such as Azospirillum brasilense, Bradyrhizobium diazoefficiens, and Methylobacterium symbioticum, whose commercial formulations rely on metabolically active cells. Even in the case of spore-forming microbes, long-term storage remains a significant challenge. To address these issues, the development of protective formulations is essential, particularly for liquid inoculants, which are more susceptible to contamination and degradation than dry powder or granular forms [14].
The development of effective solid or liquid bioinoculant formulations involves several critical steps: inoculum preparation, the addition of cell protectants, the use of appropriate carrier materials, suitable packaging, and the selection of optimal application methods [15]. In this context, a bioinoculant formulation refers to the uniform mixture of a selected beneficial microbial strain with a compatible carrier that ensures the stabilization and protection of the inoculant during transport and storage. The carrier serves as a vehicle for dormant, viable microorganisms, providing protection and a supportive niche for microbial survival and establishment [16]. Various additives can be incorporated into inoculant formulations to function as stabilizing, emulsifying, thickening, or carrier agents [17]. Among these technologies, liquid formulations represent a recent and promising advancement compared to conventional solid formulations. Since they do not rely on traditional solid carriers, liquid formulations tend to be more tolerant to temperature fluctuations and environmental stressors [16]. Additionally, beyond enhancing microbial survival during storage, additives may reduce production costs by serving as bulking agents [18]. Once applied to the soil, these additives are expected to exert beneficial effects on the soil–plant system.
Polysaccharide-based carriers and their derivatives, for instance, have been shown to stimulate plant growth [19]. However, further studies are needed to understand how soil microbiota and plants respond to such compounds and to other chemical components of microbial formulations. This is crucial as the functional role of formulation additives is often considered only in terms of bacterial viability. Fernández et al. [20], for example, demonstrated that a chitosan/starch blend in formulations containing A. brasilense Az39 and P. fluorescens ZME4 promoted maize root growth comparably to traditional inoculants. Nonetheless, few studies evaluate plant growth or physiological responses in relation to specific chemical components used in bioinoculant formulations.
To address this gap, we employed an integrative approach, combining in vitro assays with experiments using plants grown from seeds treated with inoculants, to evaluate the effects of incorporating the additives starch, CMC, and trehalose into formulations containing the microbial strains A. brasilense, B. diazoefficiens, M. symbioticum, and P. alvei. Our working hypothesis was that these additives, each with distinct functional roles, such as starch serving as a slow-release carbon source, CMC acting as a structural agent and physical stress protector, and trehalose functioning as an osmoprotectant and membrane stabilizer [21,22,23,24], modulate not only the viability of the bacterial strains during storage and post application but also exert differential effects on seed germination, the germination speed index (GSI), early development, and physiological responses (such as photochemical efficiency and photosynthetic performance) in G. max. Furthermore, we considered that the interaction between specific additives and microbial strains may lead to synergistic or antagonistic outcomes, influencing parameters such as seedling emergence, root development, and photosynthetic performance, thereby reflecting the complexity of the formulation–inoculant–host plant relationship.
2. Materials and Methods
2.1. Evaluation of Bacterial Viability
The experiment was conducted at the Applied Microbiology Laboratory of the Instituto Federal Goiano—Rio Verde Campus—between January and March 2024. Strains of Azospirillum brasilense (SVI01), Bradyrhizobium diazoefficiens (SVI02), Methylobacterium symbioticum (SVMT), and Paenibacillus alvei (SVPA), previously characterized as plant growth-promoting rhizobacteria (PGPRs), were used based on their functional traits: biological nitrogen fixation (A. brasilense, B. diazoefficiens, and M. symbioticum) and phosphate solubilization (P. alvei). Due to their differing nutritional requirements, the bacterial strains were cultured on the following specific media: nutrient agar (meat extract—1.0 g, yeast extract—2.0 g, peptone—5.0 g, sodium chloride—5.0 g, agar—15.0 g; final pH 6.8 ± 0.2; per 1000 mL of medium) for A. brasilense and M. symbioticum; LB medium (tryptone—10.0 g, yeast extract—5.0 g, NaCl—5.0 g, agar—20.0 g; final pH 7.0 ± 0.2; per 1000 mL of medium) for P. alvei; and yeast mannitol agar (YMA) (mannitol—10.0 g, K2HPO4—5.0 g, MgSO4·7H2O—2.0 g, NaCl—1.0 g, yeast extract—5.0 g, agar—20.0 g; final pH 6.8 ± 0.2; per 1000 mL of medium) for B. diazoefficiens.
These cultures were subsequently used to prepare experimental formulations aimed at enhancing cell viability over storage time. The formulations included the following additives: 1% cornstarch (Indemil®, Paranavaí, Brazil), pH 5.0, free from contaminants; 0.25% sodium carboxymethyl cellulose (CMC, Wealthy®, Changshu, China), pH 7.1, with 99.6% purity and compliant levels of heavy metals and microbial contaminants according to legal standards; and 1.5% trehalose (Hayashibara®, Okayama, Japan), pH 5.5, with 99.0% purity. These concentrations were defined based on preliminary tests, which identified additive percentages that positively influenced the viability of all tested strains after one month of storage. A control formulation consisting of the microorganism in its basal growth medium, additive-free, was also included. All formulations were stored in amber bottles and incubated in a BOD chamber (Tecnal®, Piracicaba, Brazil) at 20 °C under a 12/12 h light/dark photoperiod. Samples were evaluated at 0, 10, 20, 30, 40, 50, 60, 70, 80, and 90 days of storage. The experiment followed a completely randomized design, with four treatments (starch 1%, CMC 0.25%, trehalose 1.5%, and control) and ten storage durations. Each treatment–time combination was assessed in triplicate (Figure 1).
Figure 1.
Experimental design showing the bacterial strains (Azospirillum brasilense (SVI01), Bradyrhizobium diazoefficiens (SVI02), Methylobacterium symbioticum (SVMT), and Paenibacillus alvei (SVPA)) and storage durations (0, 10, 20, 30, 40, 50, 60, 70, 80, and 90 days) used to assess the effects of different additives, starch (1%), carboxymethyl cellulose (CMC, 0.25%), trehalose (1.5%), and a control (no additives), on the formulation and stability of bacterial inoculants.
The viability of the bacterial strains was assessed using the decimal dilution method, followed by colony-forming unit (CFU) enumeration. Serial dilutions at 10−5, 10−6, and 10−7 were prepared and plated on the respective basal media previously used (nutrient agar, LB or YMA) for initial strain cultivation. The plates were incubated in a bacteriological incubator (Alfa Mare®, Goiânia, Brazil) at 28 °C, and CFUs were counted after 10 to 12 days of incubation.
2.2. Germination and GSI Evaluation of G. max
The effect of different additives on the germination and GSI of G. max seeds was evaluated. Seeds of the cultivar Bônus 8579 RSF IPRO were treated with standardized cell concentrations (1 × 109 CFU mL−1) from the various formulations. Inoculation was carried out following the recommended rate of 100 mL of inoculant per 20 kg of seeds. As a control, seeds were treated with the respective microorganisms in their basal growth media, without any additives.
Germination percentage (%) was assessed in accordance with the Rules for Seed Testing [25]. Seeds were placed between two sheets of “germitest” paper moistened with distilled water at a volume equivalent to 2.5 times the dry weight of the substrate. The papers were rolled, placed in plastic bags, and incubated in a BOD chamber (Tecnal®, Piracicaba, Brazil) at alternating temperatures of 20–30 °C under a 12/12 h light/dark photoperiod for 14 days. Each treatment was evaluated with eight replicates of 25 seeds. To calculate the GSI, daily counts were taken of germinated seeds exhibiting a radicle length greater than 1 cm.
2.3. Growth and Physiological Evaluations in G. max Plants
The effects of different inoculant additives on soybean growth and physiology were evaluated using seeds treated as described previously. However, only formulations that had been stored for 90 days were included in this experiment. These tests were conducted in a climate-controlled greenhouse, between April and May 2024. Treated seeds were sown in 4 L pots filled with soil as the growth substrate. The soil used was a dystrophic Red Latosol, characterized in the 0–20 cm layer as follows: pH (CaCl2) 5.0; organic matter (g dm−3) 32.0; available phosphorus (mg dm−3) 8.0; potassium (mmolc dm−3) 5.5; calcium (mmolc dm−3) 20.0; magnesium (mmolc dm−3) 1.1; and potential acidity (H + Al, mmolc dm−3) 47.0. Before sowing, the soil was sampled and sieved through a 2 mm mesh. After seedling emergence, plants were thinned to maintain two plants per pot. Each treatment was evaluated with five replicates, where one replicate consisted of a pot containing two plants. Pots were irrigated daily according to plant water requirements. Biometric and physiological assessments were conducted at the R1 growth stage (first flower appearance). Physiological measurements were performed using the third fully expanded trifoliate leaf, counted from the apex toward the base.
The following biometric parameters were evaluated: plant height (cm), stem diameter (cm), shoot dry mass (leaves and stems, g), root dry mass (g), and total dry mass (g). Dry biomass was determined by drying plant material in a forced-air oven (Tecnal®, Piracicaba, Brazil) at 65 °C until constant weight, followed by the weighing of individual plant components and total biomass.
Physiological parameters included the concentration of photosynthetic pigments and measurements of chlorophyll a fluorescence and gas exchange. Photosynthetic pigment levels were estimated using a portable chlorophyll meter (ClorofiLOG CFL1030; Falker®, Porto Alegre, Brazil), providing chlorophyll a, chlorophyll b and total chlorophyll concentrations expressed as Falker Chlorophyll Index (FCI) units.
Gas exchange measurements were performed between 7:00 and 10:00 AM using an infrared gas analyzer (IRGA) equipped with an integrated fluorometer (model LI-6800XT, LI-COR Inc., Lincoln, NE, USA). The following parameters were recorded: net photosynthetic rate (A, µmol CO2 m−2 s−1), stomatal conductance (Gsw, mol H2O m−2 s−1), transpiration rate (E, mmol H2O m−2 s−1), and internal CO2 concentration (Ci, µmol CO2 mol−1).
Transient chlorophyll a fluorescence (OJIP) was measured using a portable fluorometer (FluorPen FP 100; Photon Systems Instruments, Drásov, Czech Republic). The third leaf from each plant was dark-adapted for 30 min to ensure the full oxidation of the photosynthetic electron transport chain. Subsequently, leaves were exposed to a saturating pulse of blue light at 3000 µmol m−2 s−1. Fluorescence signals were recorded at key phases: minimum fluorescence (F0, at 50 µs; all PSII reaction centers open), J-step (2 ms), I-step (30 ms), and maximum fluorescence (Fm; all PSII centers closed, P-step). These values were used to calculate several PSII bioenergetic parameters as described by Strasser et al. [26]: the specific energy absorption flux per reaction center (ABS/RC), energy dissipation at the antenna level (DI0/RC), the maximum quantum efficiency of PSII (Fv/Fm), and the photosynthetic performance index (Pi_Abs), which integrates energy flux from photon absorption to the reduction in plastoquinone (PQ).
2.4. Experimental Design and Statistical Analysis
The bacterial viability and germination experiments were designed in a completely randomized design and were conducted in a 4 × 10 double factorial scheme. The CFU data were transformed using the z-score to standardize them and reduce the influence of outliers. The z-score was calculated according to the following equation:
where x is the CFU value of the sample, μ is the mean of the CFU values of all samples and σ is the standard deviation of the CFU values.
Z = (x − μ)/σ
The Z, germination (%) and GSI values were evaluated separately for each bacterial strain and storage duration and subjected to a one-way analysis of variance (ANOVA) to test the effect of the additives. When significant differences among treatments were observed, means were compared using Tukey’s test at a 5% significance level.
For the greenhouse experiment, a randomized block design was used. The data were analyzed separately for each strain, and the effect of additives was evaluated using a one-way ANOVA. When significant differences were detected, means were also compared using Tukey’s test at the 5% probability level.
Subsequently, all variables that showed significant differences were jointly analyzed using a correlation matrix and subjected to principal component analysis (PCA). As the variables had different units of measurement, a correlation-based PCA was performed using standardized data (mean = 0, standard deviation = 1). The number of principal components was determined based on eigenvalues greater than 1.0 and cumulative explained variance exceeding 70%.
A similarity matrix was constructed to evaluate the degree of similarity or dissimilarity between treatments. The similarity index was calculated using Pearson’s correlation coefficient and converted into distance values using the formula d = (1 − r) × 100. A dendrogram was generated using the Unweighted Pair Group Method with Arithmetic Mean (UPGMA), and the goodness of fit between the distance matrix and the dendrogram was assessed using the cophenetic correlation coefficient [27]. This analysis was performed using DendroUPGMA software version 1.0 [28]. All statistical analyses were conducted using R software version 4.3.2 [29].
3. Results
The additives influenced the viability of A. brasilense only at 0 and 40 days of storage (Figure 2a). At day 0, the addition of carboxymethyl cellulose (CMC) to the formulation resulted in the highest z-score (1.66), indicating enhanced initial viability. However, at 40 days, starch was the most effective additive, yielding the highest z-score (1.48). For B. diazoefficiens, bacterial viability was significantly affected by the treatments at multiple storage intervals, specifically at 10, 20, 30, 50, 70, 80, and 90 days (Figure 2b). At 10, 20, 50, and 70 days, the addition of CMC consistently reduced bacterial viability, with corresponding z-scores of −0.54, −0.36, −0.75, and −0.57. In contrast, formulations containing trehalose tended to preserve viability more effectively across most time points (10, 20, 50, 70, 80, and 90 days), showing z-scores of 0.79, 0.45, 0.07, 0.82, 0.52, and 0.54, respectively. These values were comparable to those of the control treatment and generally higher than those observed for the other additives.

Figure 2.
The viability of bacteria in inoculant formulations prepared with different additives, starch (1%), CMC (0.25%), trehalose (1.5%), and control (no additives), and stored for different periods (0, 10, 20, 30, 40, 50, 60, 70, 80, and 90 days). Azospirillum brasilense (SVI01) (a); Bradyrhizobium diazoefficiens (SVI02) (b). CFU values were standardized using z-score transformation. Letters above the boxplots indicate statistically significant differences among treatments within each time point, as determined by Tukey’s test at the 5% significance level. Identical letters denote means that are not significantly different.
The viability of M. symbioticum was significantly affected by the additives at 20, 30, 40, 50, 60, 70, 80, and 90 days of storage (Figure 3a). Treatments containing starch and trehalose maintained higher mean viability at 20, 30, and 60 days, with respective z-scores of 1.19, 0.43, and −0.09 for starch and 0.32, 0.98, and 0.38 for trehalose. Starch also exhibited superior performance at 50 days (z-score of 1.15), while trehalose was the most effective additive at 40, 70, 80, and 90 days, with z-scores of 1.06, 1.48, 0.89, and 1.13, respectively. In formulations containing P. alvei, the effects of additives on CFU counts were observed only at 10, 70, 80, and 90 days of storage (Figure 3b). At 10 days, CMC appeared to enhance bacterial viability, yielding a z-score of 1.10. However, at 70, 80, and 90 days, the same treatment resulted in significantly lower viability compared to the others, with z-scores of −1.12, −1.05, and −1.40, respectively, indicating a negative impact on P. alvei survival during prolonged storage.

Figure 3.
The viability of bacteria in inoculant formulations prepared with different additives, starch (1%), CMC (0.25%), trehalose (1.5%), and control (no additives), and stored for different periods (0, 10, 20, 30, 40, 50, 60, 70, 80, and 90 days). Methylobacterium symbioticum (SVMT) (a); Paenibacillus alvei (SVPA) (b). CFU values were standardized using z-score transformation. Letters above the boxplots indicate statistically significant differences among treatments within each time point, as determined by Tukey’s test at the 5% significance level. Identical letters denote means that are not significantly different.
No significant effect of the different additives was observed on the germination percentage of G. max, regardless of the bacterial strain tested. Similarly, in formulations containing A. brasilense and B. diazoefficiens, the GSI was not affected by the additives at most of the storage times evaluated, except at 10 days for A. brasilense and 70 days for B. diazoefficiens. In samples inoculated with A. brasilense, the addition of starch, CMC, and trehalose resulted in higher GSI values (31.62, 30.00, and 31.20, respectively) compared to the control (24.89) (Figure 4a). For B. diazoefficiens, the addition of starch and trehalose resulted in the lowest GSI means (23.04 and 22.66, respectively).

Figure 4.
The germination speed index (GSI) of Glycine max L. seeds treated with inoculant formulations prepared with different additives, starch (1%), CMC (0.25%), trehalose (1.5%), and control (no additives), and stored for different periods (0, 10, 20, 30, 40, 50, 60, 70, 80, and 90 days). Azospirillum brasilense (SVI01) (a) and Bradyrhizobium diazoefficiens (SVI02) (b). Above the boxplots, the letters refer to the comparison of means given by the Tukey test at 5% probability. Identical letters denote means that are not significantly different.
The GSI of seeds treated with M. symbioticum formulations stored for 0 and 90 days was influenced by the type of additive used. In the 0-day formulations, the inclusion of starch, CMC, and trehalose negatively affected the GSI (23.30, 23.64, and 23.90, respectively) compared to the control treatment (28.23). However, in the 90-day formulations, the presence of starch and trehalose resulted in GSI values (26.18 and 27.08, respectively) comparable to the control (25.00) (Figure 5a). For P. alvei, the additives affected the GSI of seeds treated with formulations stored for 0, 30, and 80 days (Figure 5b). In the 0-day samples, all additives, starch, CMC, and trehalose, reduced the GSI (23.10, 23.88, and 23.51, respectively) relative to the control (26.50). In contrast, seeds treated with 30-day formulations containing CMC showed a GSI (25.72) similar to the control (26.08). At 80 days of storage, formulations with CMC and trehalose also maintained GSI values (23.79 and 23.45, respectively) statistically similar to the control (24.45).

Figure 5.
Germination speed index (GSI) of Glycine max L. seeds treated with inoculant formulations prepared with different additives, starch (1%), CMC (0.25%), trehalose (1.5%), and control (no additives), and stored for different periods (0, 10, 20, 30, 40, 50, 60, 70, 80, and 90 days). Methylobacterium symbioticum (SVMT) (a) and Paenibacillus alvei (SVPA) (b). Above the boxplots, the letters refer to the comparison of means given by the Tukey test at 5% probability. Identical letters denote means that are not significantly different.
When analyzing the growth and physiological responses of plants derived from seeds treated with inoculants containing different additives, we observed that plant height was significantly affected only in B. diazoefficiens formulations. In this case, all additives had a positive effect, resulting in increased plant height: 45.00 cm with starch, 43.37 cm with CMC, and 40.62 cm with trehalose, compared to 36.75 cm in the control treatment (Figure 6a). In contrast, stem diameter was significantly influenced only in plants treated with P. alvei formulations. The addition of CMC and trehalose negatively affected stem thickness, yielding diameters of 0.17 cm and 0.20 cm, respectively. However, the starch-containing formulation maintained a stem diameter (0.27 cm) similar to that of the control plants (0.30 cm) (Figure 6b).

Figure 6.
The growth of Glycine max L. plants obtained from seeds treated with inoculant formulations prepared with the rhizobacteria Azospirillum brasilense (SVI01), Bradyrhizobium diazoefficiens (SVI02), Methylobacterium symbioticum (SVMT) and Paenibacillus alvei (SVPA) and different additives: starch (1%), CMC (0.25%), trehalose (1.5%), and control (no additives). Plant height (a) and stem diameter (b). Above the boxplots, the letters refer to the comparison of means given by the Tukey test at 5% probability. Identical letters denote means that are not significantly different.
Additives influenced total chlorophyll content only in plants inoculated with M. symbioticum formulations. In this case, the addition of CMC reduced chlorophyll concentration in the leaves (Falker Chlorophyll Index, FCI = 29.13), while the inclusion of starch and trehalose resulted in FCI values (30.96 and 30.84, respectively) similar to the control (30.74) (Figure 7a). The dry biomass of the aerial part was affected by the additives in plants treated with formulations of A. brasilense, M. symbioticum, and P. alvei. In the case of A. brasilense, the addition of CMC led to the highest mean biomass (7.66 g). For M. symbioticum, all additives promoted an increase in shoot dry mass compared to the control (3.20 g), with values of 4.68 g for starch, 4.57 g for CMC, and 4.10 g for trehalose. In plants treated with P. alvei formulations, trehalose resulted in the greatest shoot biomass (6.40 g) (Figure 7b).

Figure 7.
Photosynthetic pigments and biomass production in Glycine max L. plants obtained from seeds treated with inoculant formulations prepared with the rhizobacteria Azospirillum brasilense (SVI01), Bradyrhizobium diazoefficiens (SVI02), Methylobacterium symbioticum (SVMT) and Paenibacillus alvei (SVPA) and different additives: starch (1%), CMC (0.25%), trehalose (1.5%), and control (no additives). Total chlorophyll, given by the Falker Chlorophyll Index (FCI) (a) and the dry mass of the aerial part (b). Above the boxplots, the letters refer to the comparison of means given by the Tukey test at 5% probability. Identical letters denote means that are not significantly different.
Similarly to the dry mass of the aerial part, root and total dry biomass were also influenced by the additives in plants treated with A. brasilense, M. symbioticum, and P. alvei. In plants inoculated with A. brasilense, the inclusion of CMC in the formulation led to a reduction in root dry mass (1.26 g), despite the shoot and total biomass being relatively high in this treatment (8.92 g) (Figure 8a,b). For plants treated with M. symbioticum, the formulation containing starch yielded the highest average values for both root (2.85 g) and total (7.53 g) dry biomass. In the case of P. alvei, although root dry mass was similar across treatments with starch, trehalose, and the control (2.12 g, 1.76 g, and 1.90 g, respectively), the total dry mass was greatest in the trehalose treatment (8.16 g), consistent with the pattern observed for the dry mass of the aerial part.

Figure 8.
Biomass production in Glycine max L. plants obtained from seeds treated with inoculant formulations prepared with the rhizobacteria Azospirillum brasilense (SVI01), Bradyrhizobium diazoefficiens (SVI02), Methylobacterium symbioticum (SVMT) and Paenibacillus alvei (SVPA) and different additives: starch (1%), CMC (0.25%), trehalose (1.5%), and control (no additives). Root dry mass (a) and total dry mass (b). Above the boxplots, the letters refer to the comparison of means given by the Tukey test at 5% probability. Identical letters denote means that are not significantly different.
The net photosynthetic rate was influenced by the presence of additives in plants inoculated with formulations of B. diazoefficiens, M. symbioticum, and P. alvei. In plants treated with B. diazoefficiens, the highest mean photosynthetic rates were recorded in the treatments with starch, CMC, and the control (14.15, 14.00, and 14.38 µmol CO2 m−2 s−1, respectively) (Figure 9a). In plants inoculated with M. symbioticum, the addition of CMC reduced the net photosynthetic rate (11.99 µmol CO2 m−2 s−1), yielding values lower than those observed in the other treatments. For P. alvei, all additives enhanced photosynthesis compared to the control, with mean rates of 13.95, 14.19, and 15.62 µmol CO2 m−2 s−1 for starch, CMC, and trehalose, respectively, versus 12.80 µmol CO2 m−2 s−1 in the control.

Figure 9.
Gas exchange parameters observed in Glycine max L. plants obtained from seeds treated with inoculant formulations prepared with the rhizobacteria Azospirillum brasilense (SVI01), Bradyrhizobium diazoefficiens (SVI02), Methylobacterium symbioticum (SVMT) and Paenibacillus alvei (SVPA) and different additives: starch (1%), CMC (0.25%), trehalose (1.5%), and control (no additives). Net photosynthetic rate (A) (a) and transpiration rate (E) (b). Above the boxplots, the letters refer to the comparison of means given by the Tukey test at 5% probability. Identical letters denote means that are not significantly different.
Additives also affected plant transpiration in treatments with A. brasilense and B. diazoefficiens. In A. brasilense-inoculated plants, the trehalose-containing formulation resulted in the highest mean transpiration rate (6.23 mmol H2O m−2 s−1). For B. diazoefficiens, all additives increased transpiration compared to the control, with the highest rates observed in the trehalose, CMC, and starch treatments (5.81, 5.46, and 4.96 mmol H2O m−2 s−1, respectively) (Figure 9b).
In plants inoculated with A. brasilense and B. diazoefficiens formulations, the additives also influenced carboxylation efficiency. For A. brasilense, the treatment containing trehalose resulted in the highest average A/Ci ratio (169.15), followed by starch and the control treatments (164.39 and 162.75, respectively) (Figure 10a). Similarly, plants inoculated with B. diazoefficiens formulations containing trehalose exhibited the highest average A/Ci (176.44), whereas the control (absence of additives) showed reduced carboxylation efficiency (156.87). Stomatal conductance was affected by additives only in plants treated with A. brasilense and B. diazoefficiens formulations. In A. brasilense-inoculated plants, trehalose treatment resulted in the highest stomatal conductance (Gsw) value (0.38 mol H2O m−2 s−1). In B. diazoefficiens treatments, the presence of additives generally increased Gsw, with the control showing a lower value of 0.26 mol H2O m−2 s−1. The trehalose, CMC, and starch treatments resulted in Gsw values of 0.35, 0.30, and 0.29 mol H2O m−2 s−1, respectively (Figure 10b).

Figure 10.
Gas exchange parameters observed in Glycine max L. plants obtained from seeds treated with inoculant formulations prepared with the rhizobacteria Azospirillum brasilense (SVI01), Bradyrhizobium diazoefficiens (SVI02), Methylobacterium symbioticum (SVMT) and Paenibacillus alvei (SVPA) and different additives: starch (1%), CMC (0.25%), trehalose (1.5%), and control (no additives). Carboxylation efficiency (A/Ci) (a) and stomatal conductance (Gsw) (b). Above the boxplots, the letters refer to the comparison of means given by the Tukey test at 5% probability. Identical letters denote means that are not significantly different.
The additives influenced the primary photochemical parameters in plants inoculated with formulations of A. brasilense, B. diazoefficiens, and M. symbioticum. Regarding the ABS/RC parameter, plants inoculated with A. brasilense were less affected when treated with trehalose and starch (3.33 and 3.34, respectively) (Figure 11a). In plants inoculated with B. diazoefficiens, the average ABS/RC value was lower in the trehalose treatment (3.12). For plants inoculated with M. symbioticum, the addition of CMC in the formulation negatively impacted chlorophyll a, as indicated by a higher mean ABS/RC value (3.92) compared to other treatments.

Figure 11.
Primary photochemistry parameters (chlorophyll a fluorescence) observed in Glycine max L. plants obtained from seeds treated with inoculant formulations prepared with the rhizobacteria Azospirillum brasilense (SVI01), Bradyrhizobium diazoefficiens (SVI02), Methylobacterium symbioticum (SVMT) and Paenibacillus alvei (SVPA) and different additives: starch (1%), CMC (0.25%), trehalose (1.5%), and control (no additives). ABS/RC (a) and DI0/RC (b). Above the boxplots, the letters refer to the comparison of means given by the Tukey test at 5% probability. Identical letters denote means that are not significantly different.
The DI0/RC parameter exhibited a pattern similar to ABS/RC. For A. brasilense, the addition of starch and trehalose reduced energy dissipation as heat (0.89 and 0.92, respectively). In plants inoculated with B. diazoefficiens, DI0/RC was also lower in the trehalose treatment (0.76). Conversely, in M. symbioticum-treated plants, CMC increased energy dissipation as heat, showing a higher DI0/RC value (1.49) (Figure 11b).
The results for Fv/Fm and Pi_Abs were consistent with those observed for ABS/RC and DI0/RC. In plants inoculated with A. brasilense, the maximum quantum efficiency of PSII (Fv/Fm) was higher in treatments with starch and trehalose (0.73 and 0.72, respectively) (Figure 12a). In plants treated with B. diazoefficiens, the Fv/Fm parameter was highest in the trehalose treatment (0.76). Conversely, in plants inoculated with M. symbioticum formulations, treatment with CMC reduced PSII photochemical efficiency (0.61), while the highest values were observed in treatments with trehalose, starch, and the control (0.72, 0.70, and 0.70, respectively). For plants treated with P. alvei, a reduction in Fv/Fm was observed when trehalose was added to the formulation (0.65).

Figure 12.
Primary photochemistry parameters (chlorophyll a fluorescence) observed in Glycine max L. plants obtained from seeds treated with inoculant formulations prepared with the rhizobacteria Azospirillum brasilense (SVI01), Bradyrhizobium diazoefficiens (SVI02), Methylobacterium symbioticum (SVMT) and Paenibacillus alvei (SVPA) and different additives: starch (1%), CMC (0.25%), trehalose (1.5%), and control (no additives). Fv/Fm (a) and Pi_Abs (b). Above the boxplots, the letters refer to the comparison of means given by the Tukey test at 5% probability. Identical letters denote means that are not significantly different.
Similarly, the photosynthetic performance index (Pi_Abs) in plants inoculated with A. brasilense was higher in treatments containing trehalose and starch (0.79 and 0.72, respectively) (Figure 12b). In plants treated with B. diazoefficiens, Pi_Abs was also highest with trehalose (1.02). However, in plants inoculated with M. symbioticum, CMC reduced Pi_Abs (0.16), with trehalose, starch, and control treatments showing higher values (0.62, 0.54, and 0.52, respectively). No significant effect of the additives on Pi_Abs was observed in plants treated with P. alvei formulations.
When evaluating the relationships among the analyzed variables, we observed that, in general, in plants inoculated with A. brasilense, the starch additive showed superior performance in maintaining cell viability, promoting plant growth, and enhancing chlorophyll a fluorescence. This was associated with higher average CFU counts, increased plant height, greater total dry biomass, and higher concentrations of total chlorophyll in the leaves. Additionally, these plants exhibited higher Fv/Fm values and lower energy dissipation as heat (DI0/RC), indicating a more efficient use of absorbed light energy (Figure 13a). In plants inoculated with B. diazoefficiens, the addition of trehalose to the inoculant improved carboxylative performance and photochemical efficiency. This was associated with higher chlorophyll concentrations, an increased transpiration rate (E), enhanced carboxylation efficiency (A/Ci), and greater stomatal conductance (Gsw). This treatment also resulted in the highest photochemical efficiencies (Fv/Fm and Pi_Abs) and the lowest indications of damage in primary fluorescence parameters (ABS/RC and DI0/RC). Conversely, CMC was associated with the lowest average dry mass of both the aerial and total plant parts (Figure 13b).

Figure 13.
Principal component analysis involving variables of cell viability (CFU), germination speed index (GSI), growth, gas exchange and chlorophyll a fluorescence evaluated in Glycine max L. plants obtained from seeds treated with inoculant formulations prepared with the rhizobacteria Azospirillum brasilense (SVI01) and Bradyrhizobium diazoefficiens (SVI02), and different additives: starch (1%), CMC (0.25%), trehalose (1.5%), and control (no additives). A. brasilense (a) and B. diazoefficiens (b). DMPA = dry mass of aerial part, DMR = dry mass of root, TDM = total dry mass.
In plants inoculated with M. symbioticum, the addition of starch led to enhanced plant performance by promoting greater bacterial viability, improved carboxylation efficiency, and increased biomass accumulation. Starch specifically stimulated root dry mass and total dry mass production. Additionally, both starch and trehalose supported higher CFU counts and resulted in the highest average concentrations of total chlorophyll, which was accompanied by an improved transpiration rate (E), carboxylation efficiency (A/Ci), and stomatal conductance (Gsw) in the leaves. Additionally, these treatments resulted in the highest photochemical efficiencies (Fv/Fm and Pi_Abs) and the lowest damage to primary fluorescence parameters (ABS/RC and DI0/RC). Conversely, CMC was associated with the lowest total chlorophyll content, which corresponded with reduced gas exchange parameters and increased stress on chlorophyll a (Figure 14a).

Figure 14.
Principal component analysis involving variables of cell viability (CFU), germination speed index (GSI), growth, gas exchange and chlorophyll a fluorescence evaluated in Glycine max L. plants obtained from seeds treated with inoculant formulations prepared with the rhizobacteria Methylobacterium symbioticum (SVMT) and Paenibacillus alvei (SVPA), and different additives: starch (1%), CMC (0.25%), trehalose (1.5%), and control (no additives). M. symbioticum (a) and P. alvei (b). DMPA = dry mass of aerial part, DMR = dry mass of root, TDM = total dry mass.
The PCA for P. alvei data, however, revealed inconclusive trends. While starch and trehalose treatments correlated with higher average growth, trehalose also increased the net photosynthesis rate (A) and stomatal conductance (Gsw) but appeared to reduce photochemical efficiency (Fv/Fm and Pi_Abs) and induce stress responses in PSII (ABS/RC and DI0/RC) (Figure 14b).
4. Discussion
4.1. Starch Had a Positive Effect on Cell Viability in A. brasilense Formulations. In M. symbioticum, Both Starch and Trehalose Showed Beneficial Effects. In Contrast, CMC Negatively Affected the Viability of B. diazoefficiens and P. alvei During Storage
Starch can help maintain bacterial cell viability in formulations through several mechanisms, particularly when used as an excipient or support agent in dry or liquid probiotic or biofertilizer formulations (e.g., [17,30,31,32]). The mechanisms by which starch contributes to bacterial viability include the following: Protection against osmotic stress and dehydration—Starch can help preserve the integrity of cell membranes and minimize protein denaturation, thereby protecting bacterial cells from osmotic stress and dehydration [33]. Formation of a protective physical matrix—Starch (or its derivatives, such as maltodextrin) can encapsulate bacterial cells in an amorphous or semicrystalline matrix, limiting exposure to oxygen, light, and moisture and reducing the action of oxidizing agents or external enzymes (e.g., [34,35,36,37]).
Starch has an advantage over other additives because it is chemically inert, facilitating its combination with other stabilizers (such as calcium alginate, sodium alginate, and bentonite), further optimizing protection for bacterial cells [38,39,40]. Polymeric additives, such as polyvinylpyrrolidone (PVP), polyvinyl alcohol (PVA), and starch, have protective polymeric properties [41]. Biopolymer-based encapsulation protects microorganisms against adverse environmental conditions, improving their shelf life and release into the soil or plant shoots [42]. The protective property of biopolymers is known as colloidal stabilization, where bacteria represent one colloid and the suspension of the other [43].
CMC/starch mixtures have demonstrated potential for use as carriers for liquid and gel-based formulations, maintaining the viability of a mixture of five strains of diazotrophic bacteria (Gluconacetobacter diazotrophicus, Herbaspirillum seropedicae, H. rubrisubalbicans, Azospirillum amazonense, and Burkholderia tropica) [44]. A greenhouse experiment showed that inoculated sugarcane responded positively to colonization by diazotrophic strains. Almeida et al. [45] optimized CMC/starch mixtures for their application as inoculation carriers for a strain of B. pachyrhizi, demonstrating that the viability of this bacterium responds positively to polymeric additives such as starch.
Trehalose, a natural disaccharide, has cell stabilization properties proven in several studies [46,47] and has been widely used to maintain the viability of bacterial cells in different agricultural formulations, such as biofertilizers and biopesticides [13]. This sugar acts as a stabilizing agent, replacing water in the cellular structure, interacting with membrane phospholipids, preserving their integrity, and stabilizing proteins through hydrogen bonds [48]. The mechanism underlying its protective effect is known as the ‘water replacement hypothesis’ and is related to the ability of trehalose to lower the phase transition temperature of phospholipids in the membrane by replacing the water molecules around the lipid head groups [49]. This helps maintain membrane fluidity and integrity. Studies have shown that trehalose can promote a cytoplasmic vitrification state, immobilizing cellular components and preventing unwanted chemical reactions [50]. In this way, trehalose isolates cells from external factors, such as oxygen, light, and moisture, prolonging cell viability during storage [51]. Additionally, trehalose is thermostable, protecting cells during storage under suboptimal conditions, and because it is chemically inert, non-reducing, and highly soluble in water, it can be easily combined with starch and other excipients, being applied to liquid and solid formulations [52,53].
Chompa et al. [54] demonstrated that the addition of 10 nM trehalose has the potential to extend the shelf life of PGPRs by maintaining cell viability. In their study, bacterial populations of Bacillus tequilensis and Bacillus aryabhattai supplemented with 10 nM trehalose were compared to cultures supplemented with 5 mM glycerol and 1% PVP. Trehalose proved to be more effective in minimizing cell mortality after three months of storage. Similarly, Gopi et al. [55] found that formulations containing 15 mM trehalose consistently exhibited the highest viable cell counts up to 18 months across different PGPR strains. These authors attributed the improved survival to the trehalose-induced synthesis of stress-protective metabolites, which help maintain cellular integrity under adverse conditions.
Carboxymethylcellulose (CMC) is widely used in agricultural inoculants as a thickening agent, stabilizer, and matrix-forming component [32,56]. While CMC is generally not recognized as toxic to bacterial cells, its interactions may vary depending on several factors, such as concentration. Concentrations commonly used in formulations are around 0.2%; however, higher concentrations can increase osmolarity or form a highly viscous matrix that impairs nutrient and oxygen diffusion [57]. The study by Niu et al. [58] demonstrated that CMC forms colloidal complexes with proteins, specifically ovalbumin, through electrostatic interactions that induce conformational changes and promote the formation of more compact aggregates. These findings suggest that, in bacterial formulations, similar interactions may occur between CMC and surface components such as membrane proteins or cell wall polysaccharides, potentially leading to structural destabilization and the inhibition of bacterial growth.
Since CMC is a sodium salt, the presence of Na+ ions can alter the pH of the formulation and disrupt the osmotic balance [59], potentially leading to a loss of cell viability. Furthermore, commercial-grade CMC may contain impurities that are harmful to sensitive microorganisms. In our study, the comparatively lower protective effect of CMC on cell viability is likely associated with the relatively low concentration used (0.25%), although the optimal concentration is known to vary depending on the bacterial species. For example, Dal Bello et al. [60] achieved an effective protection of Trichoderma spp. using 1% CMC.
On the other hand, the addition of starch, CMC, and trehalose at the tested concentrations did not improve the performance of A. brasilense, B. diazoefficiens, M. symbioticum, or P. alvei formulations with respect to the germination speed index (GSI). In fact, these additives negatively affected the GSI in treatments with M. symbioticum and P. alvei at day 0. It is possible that the additives formed a film on the seed surface, thereby delaying radicle protrusion; however, this did not lead to reductions in subsequent plant growth. Our findings highlight the importance of considering formulation properties in future studies, with the goal of enhancing the effects of microbial inoculants on seed germination and improving product performance under field conditions.
4.2. The Starch Present in A. brasilense and M. symbioticum Formulations Indirectly Improved Growth and Physiology Parameters of G. max Plants
These formulations led to taller plants with greater total dry mass and higher concentrations of total chlorophyll in the leaves, as well as increased maximum quantum efficiency and reduced energy dissipation as heat in plants inoculated with A. brasilense. In plants inoculated with M. symbioticum, starch-based formulations stimulated root and total dry biomass accumulation and promoted higher carboxylation efficiency. This effect may be attributed to starch’s capacity to enhance the performance of PGPRs, such as A. brasilense and Pseudomonas fluorescens, even though starch is not directly applied as a nutrient [20]. Studies have shown that starch can maintain bacterial activity within formulations by serving as an energy source, particularly after application to soil or seeds [61]. This is especially relevant in soils with low moisture or organic matter content. Starch can provide carbon to PGPRs, keeping them metabolically active [62], which may positively influence the expression of functional traits such as biological nitrogen fixation, nutrient solubilization, and phytohormone production. Additionally, starch can function as an adhesive in formulations, enhancing inoculant adherence to seed surfaces [63].
Research supports starch’s ability to physically protect bacteria by forming a matrix around cells during storage, thereby minimizing oxidative damage [19]. Under stress conditions, the protective effect of starch on microbial cells is primarily based on cell adhesion. This interaction depends on surface tension and the balance between cell adhesion to starch and starch utilization as a substrate [61]. In bioencapsulation systems, starch has been shown to reduce mechanical stress on microbial cells and significantly improve survival rates [64]. Alginate–starch-based formulations have also been used successfully to encapsulate mycoherbicidal strains of Fusarium oxysporum, resulting in high viability, extended shelf life, and effective rhizosphere colonization [65]. Moreover, some bacteria utilize starch as a carbon source for the production of exopolysaccharides (EPSs) [66], which facilitate biofilm formation on plant roots. These biofilms enhance bacterial adhesion, provide protection, and promote nutrient exchange, thereby improving plant–microbe interactions [67]. Furthermore, the polymeric nature of starch contributes to water retention in the rhizosphere, creating a more stable and humid microenvironment that supports both root and microbial activity [68].
4.3. Trehalose Improved the Growth and Physiological Performance of G. max in B. diazoefficiens Formulations and Enhanced Gas Exchange and Photochemical Parameters in M. symbioticum Formulations
The effects observed in G. max are likely due to the indirect action of trehalose. Trehalose functions as a stabilizing and protective agent for microbial cells, producing beneficial effects on bacteria and, consequently, on the plants they colonize. As a protective sugar, trehalose stabilizes proteins and cell membranes, shielding them from thermal stress, denaturation, and oxidative damage [13,53,69]. Studies have shown that trehalose enhances bacterial osmotolerance, facilitating more effective root colonization and nodulation by PGPRs [70]. As a result, the improved colonization may enhance the expression of functional bacterial traits, leading to increased nutrient uptake and more vigorous plant development (e.g., [71,72]).
Several bacterial species naturally synthesize trehalose [73,74], which contributes to plant stress tolerance and supports growth under adverse environmental conditions [75]. Orozco-Mosqueda et al. [76] demonstrated that the synergistic activity of ACC deaminase and trehalose produced by Pseudomonas sp. UW4 enhances tomato tolerance to salt stress. Furthermore, by increasing the stability of bacterial formulations, trehalose can improve inoculant efficacy, potentially leading to greater crop productivity. Due to its biological relevance, trehalose is a major disaccharide found in legume root nodules and is present at high concentrations in bacteroids during the onset of nitrogen fixation [77]. It is the predominant carbohydrate in cultures of Bradyrhizobium strains and has also been detected in cultures of other rhizobia, including Sinorhizobium meliloti and Rhizobium leguminosarum bv. trifolii, viciae, and phaseoli [78]. Notably, trehalose accumulation has been strongly associated with microbial tolerance to environmental stressors and long-term survival under hostile conditions [75,79,80].
4.4. The Presence of CMC in M. symbioticum Formulations Negatively Impacted Gas Exchange Parameters and Chlorophyll a Fluorescence in G. max Plants
Carboxymethyl cellulose (CMC) is a cellulose-derived polysaccharide commonly used in bacterial formulations as a thickening and suspending agent [17]. While generally regarded as biocompatible and safe [81], CMC may negatively impact plant physiology under certain conditions, particularly when applied at high concentrations or in unsuitable formulations. When used excessively, CMC can form a gelatinous film around seeds or roots, potentially limiting oxygen diffusion, impairing root respiration, and restricting the movement of water and nutrients in the rhizosphere. These effects may result in reduced early plant growth and symptoms of nutrient deficiency.
Additionally, impurities found in commercial CMC, such as residual sodium or chemical preservatives, can alter the pH at the soil application site, consequently affecting plant physiology and growth [82]. Variations in soil pH may influence nutrient availability and microbial enzyme activity [83,84]. In the present study, inoculants were formulated using low concentrations of CMC, which nonetheless resulted in reduced bacterial viability in B. diazoefficiens and P. alvei formulations. Although food-grade CMC was used, it is important to note that some commercial sources may contain traces of heavy metals, such as lead or arsenic. Typically, polymer batches are evaluated for these and other contaminants, including microbial impurities. Safer alternatives to CMC, such as hydroxypropyl methylcellulose (HPMC) or sodium alginate, have been proposed in the literature [85]. On the other hand, studies have shown that CMC can perform well at optimized concentrations, particularly when combined with other carrier materials. Co-formulations such as CMC/starch and CMC/poloxamer have been effective in preserving the viability of Bradyrhizobium pachyrhizi cells and Trichoderma afroharzianum spores, respectively [45,86].
The results for plants inoculated with P. alvei were inconclusive, which may be attributed to the morphological state of the bacterium in the formulation. As an endospore-forming species [87], the impact of additives on its viability and resilience may be less evident, particularly when the storage duration is short. Nevertheless, we recommend that future studies investigate formulations with a broader range of concentrations of starch, CMC, and trehalose, as well as alternative stabilizing agents available on the market, such as PVP, sorbitol, and xanthan gum, to more comprehensively evaluate their influence on P. alvei performance. Our findings highlight that the choice of additives in inoculant formulations is critical not only for microbial viability but also for physiological responses in G. max. However, further research is necessary to deepen our understanding of the interactions between microbial strains, formulation additives, and environmental conditions at the application site, with the goal of enhancing inoculant efficacy in soybean cultivation.
5. Conclusions
The starch additive proved effective in preserving the cell viability of A. brasilense, and a similar effect was observed for M. symbioticum when using both starch and trehalose. These additives also promoted beneficial effects on the growth and physiological performance of G. max, including increased shoot dry biomass, higher total chlorophyll content, enhanced carboxylation efficiency (A/Ci), and improved photochemical parameters (Fv/Fm and Pi_Abs). Trehalose, in particular, stood out for enhancing physiological responses in formulations with B. diazoefficiens and M. symbioticum, indicating its potential as a versatile and effective stabilizer in bioinoculant formulations. Conversely, although CMC is commonly employed as a structuring agent in microbial formulations, it exhibited inferior performance at the tested concentration (0.25%). Specifically, it reduced the viability of B. diazoefficiens and P. alvei and negatively impacted physiological parameters in G. max when combined with M. symbioticum. These findings underscore the importance of carefully selecting additives for inoculant formulations, considering not only their compatibility with specific microbial strains but also their indirect effects on the host plant. Such considerations are essential for developing more efficient and stable products that support sustainable agricultural practices.
Author Contributions
Conceptualization, L.C.V. and L.A.B.; methodology, L.C.V.; formal analysis, F.R.S.d.C. and B.G.C.; investigation, M.B.T.; resources, F.R.S.d.C. and B.G.C.; writing—original draft preparation, F.R.S.d.C.; writing—review and editing, L.C.V.; visualization, L.C.V.; supervision, L.A.B. and M.B.T.; project administration, L.A.B.; funding acquisition, M.B.T. All authors have read and agreed to the published version of the manuscript.
Funding
This research received no external funding.
Data Availability Statement
All the data relevant to this manuscript are available on request from the corresponding author.
Acknowledgments
The authors would like to thank the Coordination for the Improvement of Higher Education Personnel (CAPES), the Foundation for Research Support of the State of Goiás (FAPEG), and the IFGoiano, Rio Verde Campus, for the infrastructure and the students involved in this study.
Conflicts of Interest
Authors Layara Alexandre Bessa, Bárbara Gonçalves Cruvinel and Luciana Cristina Vitorino are employed by Simple Agro Corporation. The remaining authors declare that this research was conducted in the absence of any commercial or financial relationships that could be construed as potential conflicts of interest.
References
- Fiuza, D.A.F.; Vitorino, L.C.; Silva, C.F.D.; Trombela, N.T.D.S.; Ventura, M.V.A.; Bessa, L.A.; Souchie, E.L. Plant growth-promoting rhizobacteria isolated from cultivated soils using Glycine max L. plants as bait. Ciênc. Rural 2023, 54, e20220684. [Google Scholar] [CrossRef]
- Fatmawati, U.; Sari, D.P.; Santosa, S.; Wiraswati, S.M. IAA-producing and phosphate solubilizer of rhizosphere actinobacteria consortium to promote plant growth in soybean (Glycine max L.). Asian J. Agric. Biol. 2023, 4, 1–9. [Google Scholar] [CrossRef]
- Yaghoubian, I.; Modarres-Sanavy, S.A.M.; Smith, D.L. Plant growth promoting microorganisms (PGPM) as an eco-friendly option to mitigate water deficit in soybean (Glycine max L.): Growth, physio-biochemical properties and oil content. Plant Physiol. Biochem. 2022, 191, 55–66. [Google Scholar] [CrossRef] [PubMed]
- Naamala, J.; Smith, D.L. Relevance of plant growth promoting microorganisms and their derived compounds, in the face of climate change. Agronomy 2020, 10, 1179. [Google Scholar] [CrossRef]
- Chesneau, G.; Torres-Cortes, G.; Briand, M.; Darrasse, A.; Preveaux, A.; Marais, C.; Jacques, M.-A.; Shade, A.; Barret, M. Temporal dynamics of bacterial communities during seed development and maturation. FEMS Microbiol. Ecol. 2020, 96, fiaa190. [Google Scholar] [CrossRef]
- Kuzhuppillymyal-Prabhakarankutty, L.; Tamez-Guerra, P.; Gomez-Flores, R.; Rodriguez-Padilla, M.C.; Ek-Ramos, M.J. Endophytic Beauveria bassiana promotes drought tolerance and early flowering in corn. World J. Microbiol. Biotechnol. 2020, 36, 47. [Google Scholar] [CrossRef]
- Yagmur, B.; Gunes, A. Evaluation of the effects of plant growth promoting rhizobacteria (PGPR) on yield and quality parameters of tomato plants in organic agriculture by principal component analysis (PCA). Gesunde Pflanz. 2021, 73, 219–228. [Google Scholar] [CrossRef]
- Dowarah, B.; Gill, S.S.; Agarwala, N. Arbuscular mycorrhizal fungi in conferring tolerance to biotic stresses in plants. J. Plant Growth Regul. 2021, 41, 1429–1444. [Google Scholar] [CrossRef]
- Khoshru, B.; Mitra, D.; Khoshmanzar, E.; Myo, E.M.; Uniyal, N.; Mahakur, B.; Mohapatra, P.K.; Panneerselvam, P.; Boutaj, H.; Alizadeh, M.; et al. Current scenario and future prospects of plant growth-promoting rhizobacteria: An economic valuable resource for the agriculture revival under stressful conditions. J. Plant Nutr. 2020, 43, 3062–3092. [Google Scholar] [CrossRef]
- Basu, A.; Prasad, P.; Das, S.N.; Kalam, S.; Sayyed, R.Z.; Reddy, M.S.; El Enshasy, H. Plant growth promoting rhizobacteria (PGPR) as green bioinoculants: Recent developments, constraints, and prospects. Sustainability 2021, 13, 1140. [Google Scholar] [CrossRef]
- Koskey, G.; Mburu, S.W.; Awino, R.; Njeru, E.M.; Maingi, J.M. Potential use of beneficial microorganisms for soil amelioration, phytopathogen biocontrol, and sustainable crop production in smallholder agroecosystems. Front. Sustain. Food Syst. 2021, 5, 130. [Google Scholar] [CrossRef]
- Santos, M.S.; Nogueira, M.A.; Hungria, M. Microbial inoculants: Reviewing the past, discussing the present and previewing an outstanding future for the use of beneficial bacteria in agriculture. AMB Express 2019, 9, 22. [Google Scholar] [CrossRef] [PubMed]
- Berninger, T.; González López, Ó.; Bejarano, A.; Preininger, C.; Sessitsch, A. Maintenance and assessment of cell viability in formulation of non-sporulating bacterial inoculants. Microb. Biotechnol. 2018, 11, 277–301. [Google Scholar] [CrossRef] [PubMed]
- Bashan, Y.; de-Bashan, L.E.; Prabhu, S.R.; Hernandez, J.P. Advances in plant growth-promoting bacterial inoculant technology: Formulations and practical perspectives (1998–2013). Plant Soil 2014, 378, 1–33. [Google Scholar] [CrossRef]
- Zayed, M.S. Advances in formulation development technologies. In Microbial Inoculants in Sustainable Agricultural Productivity, 2nd ed.; Singh, D., Singh, H., Prabha, R., Eds.; Springer: New Delhi, India, 2016; pp. 219–237. [Google Scholar] [CrossRef]
- Chaudhary, T.; Dixit, M.; Gera, R.; Shukla, A.K.; Prakash, A.; Gupta, G.; Shukla, P. Techniques for improving formulations of bioinoculants. 3 Biotech 2020, 10, 199. [Google Scholar] [CrossRef]
- Jaiswal, A.; Kumari, G.; Upadhyay, V.K.; Pradhan, J.; Pramanik, H.S.K. A methodology to develop liquid formulation of biofertilizer technology. Pharma Innov. J. 2023, 12, 875–881. [Google Scholar]
- Dianawati, D.; Mishra, V.; Shah, N.P. Survival of microencapsulated probiotic bacteria after processing and during storage: A review. Crit. Rev. Food Sci. Nutr. 2016, 56, 1685–1716. [Google Scholar] [CrossRef]
- Vassilev, N.; Vassileva, M.; Martos, V.; Garcia del Moral, L.F.; Kowalska, J.; Tylkowski, B.; Malusá, E. Formulation of microbial inoculants by encapsulation in natural polysaccharides: Focus on beneficial properties of carrier additives and derivatives. Front. Plant Sci. 2020, 11, 270. [Google Scholar] [CrossRef]
- Fernández, M.; Pagnussat, L.A.; Borrajo, M.P.; Perez Bravo, J.J.; Francois, N.J.; Creus, C.M. Chitosan/starch beads as bioinoculants carrier: Long-term survival of bacteria and plant growth promotion. Appl. Microbiol. Biotechnol. 2022, 106, 7963–7972. [Google Scholar] [CrossRef]
- Velloso, C.C.; Borges, R.; Badino, A.C.; Oliveira-Paiva, C.A.; Ribeiro, C.; Farinas, C.S. Modulation of starch-based film properties for encapsulation of microbial inoculant. Int. J. Biol. Macromol. 2024, 283, 137605. [Google Scholar] [CrossRef]
- Liu, L.; Xie, S.; Zhu, Y.; Zhao, H.; Zhang, B. Sodium carboxymethyl celluloses as a cryoprotectant for survival improvement of lactic acid bacterial strains subjected to freeze-drying. Int. J. Biol. Macromol. 2024, 260, 129468. [Google Scholar] [CrossRef] [PubMed]
- França, C.R.R.S.; Lira Junior, M.A.; Figueiredo, M.D.V.B.; Stamford, N.P.; Silva, G.A. Feasibility of rhizobia conservation by liquid conditioners. Rev. Ciênc. Agron. 2013, 44, 661–668. [Google Scholar] [CrossRef]
- Maiti, A.; Daschakraborty, S. Unraveling the molecular mechanisms of trehalose-mediated protection and stabilization of Escherichia coli lipid membrane during desiccation. J. Phys. Chem. B 2023, 127, 4496–4507. [Google Scholar] [CrossRef] [PubMed]
- Brasil; Ministério da Agricultura e Reforma Agrária, Coordenação de Laboratório Vegetal. Regras Para Análise de Sementes; Ministério da Agricultura e Reforma Agrária, Coordenação de Laboratório Vegetal: Brasília, Brazil, 2009. [Google Scholar]
- Strasser, R.J.; Srivastava, A.; Tsimilli-Michael, M. The fluorescence transient as a tool to characterize and screen photosynthetic samples. In Probing Photosynthesis: Mechanisms, Regulation and Adaptation; Yunus, M., Pathre, U., Mohanty, P., Eds.; CCR Press: London, UK; New York, NY, USA, 2000; pp. 445–483. [Google Scholar]
- Sokal, R.R.; Rohlf, F.J. The comparison of dendrograms by objective methods. Taxon 1962, 11, 33–40. [Google Scholar] [CrossRef]
- Garcia-Vallve, S.; Palau, J.; Romeu, A. Horizontal gene transfer in glycosyl hydrolases inferred from codon usage in Escherichia coli and Bacillus subtilis. Mol. Biol. Evol. 1999, 16, 1125–1134. [Google Scholar] [CrossRef]
- R Core Team. R: A Language and Environment for Statistical Computing; R Foundation for Statistical Computing: Vienna, Austria, 2024; Available online: https://www.R-project.org/ (accessed on 27 December 2024).
- Sharma, H.; Sharma, S.; Bajwa, J.; Chugh, R.; Kumar, D. Polymeric carriers in probiotic delivery system. Carbohydr. Polym. Technol. Appl. 2023, 5, 100301. [Google Scholar] [CrossRef]
- Kawakita, R.; Leveau, J.H.; Jeoh, T. Optimizing viability and yield and improving stability of Gram-negative, non-spore forming plant-beneficial bacteria encapsulated by spray-drying. Bioprocess Biosyst. Eng. 2021, 44, 2289–2301. [Google Scholar] [CrossRef]
- Fernandes Júnior, P.I.; Rohr, T.G.; Oliveira, P.J.D.; Xavier, G.R.; Rumjanek, N.G. Polymers as carriers for rhizobial inoculant formulations. Pesqui. Agropecu. Bras. 2009, 44, 1184–1190. [Google Scholar] [CrossRef]
- Schoebitz, M.; Simonin, H.; Poncelet, D. Starch filler and osmoprotectants improve the survival of rhizobacteria in dried alginate beads. J. Microencapsul. 2012, 29, 532–538. [Google Scholar] [CrossRef]
- Viana, J.L.; da Silva, J.S.; de Mattos, G.C.; Pinto, M.C.; Dutra, L.D.S.; Carvalho, L.L.D.A.; Pinto, J.C.C.S.; Pinheiro, V.C.S.; Roque, R.A. Microencapsulation of Bacillus thuringiensis strains for the control of Aedes aegypti. Exp. Parasitol. 2023, 255, 108654. [Google Scholar] [CrossRef]
- Saavedra-Leos, M.Z.; Román-Aguirre, M.; Toxqui-Terán, A.; Espinosa-Solís, V.; Franco-Vega, A.; Leyva-Porras, C. Blends of carbohydrate polymers for the co-microencapsulation of Bacillus clausii and quercetin as active ingredients of a functional food. Polymers 2022, 14, 236. [Google Scholar] [CrossRef] [PubMed]
- Li, Z.; Sun, B.; Zhu, Y.; Liu, L.; Huang, Y.; Lu, M.; Zhu, X.; Gao, Y. Efeito da maltodextrina na estabilidade oxidativa de microcápsulas de corpos de óleo de soja induzidos por ultrassom. Front. Nutr. 2022, 9, 1071462. [Google Scholar] [CrossRef]
- Ma, X.; Wang, X.; Cheng, J.; Nie, X.; Yu, X.; Zhao, Y.; Wang, W. Microencapsulation of Bacillus subtilis B99-2 and its biocontrol efficiency against Rhizoctonia solani in tomato. Biol. Control 2015, 90, 34–41. [Google Scholar] [CrossRef]
- Saberi-Rise, R.; Moradi-Pour, M. The effect of Bacillus subtilis Vru1 encapsulated in alginate–bentonite coating enriched with titanium nanoparticles against Rhizoctonia solani on bean. Int. J. Biol. Macromol. 2020, 152, 1089–1097. [Google Scholar] [CrossRef]
- He, Y.; Wu, Z.; Ye, B.-C.; Wang, J.; Guan, X.; Zhang, J. Viability evaluation of alginate-encapsulated Pseudomonas putida Rs-198 under simulated salt-stress conditions and its effect on cotton growth. Eur. J. Soil Biol. 2016, 75, 135–141. [Google Scholar] [CrossRef]
- Wu, L.Z.; Guo, S.; Qin, C.; Li, C. Encapsulation of R. planticola Rs-2 from alginate–starch–bentonite and its controlled release and swelling behavior under simulated soil conditions. J. Ind. Microbiol. Biotechnol. 2012, 39, 317–327. [Google Scholar] [CrossRef]
- Lopes, M.M.; Lodi, L.A.; Oliveira-Paiva, C.A.D.; Farinas, C.S. Emulsion/cross-linking encapsulation of Bacillus in starch/PVA-based microparticles for agricultural applications. ACS Agric. Sci. Technol. 2024, 4, 490–499. [Google Scholar] [CrossRef]
- Martău, G.A.; Mihai, M.; Vodnar, D.C. The use of chitosan, alginate, and pectin in the biomedical and food sector—Biocompatibility, bioadhesiveness, and biodegradability. Polymers 2019, 11, 1837. [Google Scholar] [CrossRef]
- Deaker, R.; Roughley, R.J.; Kennedy, I.R. Legume seed inoculation technology—A review. Soil Biol. Biochem. 2004, 36, 1275–1288. [Google Scholar] [CrossRef]
- Silva, M.F.D.; Oliveira, P.J.D.; Xavier, G.R.; Rumjanek, N.G.; Reis, V.M. Inoculants containing polymers and endophytic bacteria for the sugarcane crop. Pesqui. Agropecu. Bras. 2009, 44, 1437–1443. [Google Scholar] [CrossRef]
- Almeida, J.C.D.; Favero, V.O.; Rouws, J.R.C.; Freitas, C.D.S.A.; Sousa, É.B.D.; Rocha, J.F.D.; Chantre, N.C.S.; Xavier, G.R.; Oliveira, P.J.; Rumjanek, N.G. Inoculant formulation for Bradyrhizobium spp.: Optimizing CMC/starch blends for improved performance. Agriculture 2025, 15, 1010. [Google Scholar] [CrossRef]
- Li, Y.; Jiang, G.; Long, H.; Liao, Y.; Wu, L.; Huang, W.; Liu, X. Contribution of trehalose to ethanol stress tolerance of Wickerhamomyces anomalus. BMC Microbiol. 2023, 23, 239. [Google Scholar] [CrossRef] [PubMed]
- Herdeiro, R.S.; Pereira, M.D.; Panek, A.D.; Eleutherio, E.C.A. Trehalose protects Saccharomyces cerevisiae from lipid peroxidation during oxidative stress. Biochim. Biophys. Acta Gen. Subj. 2006, 1760, 340–346. [Google Scholar] [CrossRef] [PubMed]
- Kuczyńska-Wiśnik, D.; Stojowska-Swędrzyńska, K.; Laskowska, E. Intracellular protective functions and therapeutical potential of trehalose. Molecules 2024, 29, 2088. [Google Scholar] [CrossRef]
- Leslie, S.B.; Israeli, E.; Lighthart, B.; Crowe, J.H.; Crowe, L.M. Trehalose and sucrose protect both membranes and proteins in intact bacteria during drying. Appl. Environ. Microbiol. 1995, 61, 3592–3597. [Google Scholar] [CrossRef]
- Potts, M. Desiccation tolerance of prokaryotes. Microbiol. Rev. 1994, 58, 755–805. [Google Scholar] [CrossRef]
- Aukema, K.G.; Wang, M.; de Souza, B.; O’Keane, S.; Clipsham, M.; Wackett, L.P.; Aksan, A. Core-shell encapsulation formulations to stabilize desiccated Bradyrhizobium against high environmental temperature and humidity. Microb. Biotechnol. 2022, 15, 2391–2400. [Google Scholar] [CrossRef]
- Nelson, B.; Wilcox, C. Trehalose: A Powerful Excipient in the Formulation Toolbox. 2015. Available online: https://drug-dev.com/trehalose-a-powerful-excipient-in-the-formulation-toolbox/ (accessed on 6 February 2025).
- Lee, J.; Lin, E.W.; Lau, U.Y.; Hedrick, J.L.; Bat, E.; Maynard, H.D. Trehalose glycopolymers as excipients for protein stabilization. Biomacromolecules 2013, 14, 2561–2569. [Google Scholar] [CrossRef]
- Chompa, S.S.; Zuan, A.; Amin, A.M.; Hun, T.G.; Hamzah, A.; Nabayi, A. Carrier based liquid bio-formulation of salt-tolerant PGPR Bacillus species for prolonged survivability. Sains Malays. 2024, 53, 1055–1065. [Google Scholar] [CrossRef]
- Gopi, G.K.; Meenakumari, K.S.; Nysanth, N.S.; Subha, P. An optimized standard liquid carrier formulation for extended shelf-life of plant growth promoting bacteria. Rhizosphere 2019, 11, 100160. [Google Scholar] [CrossRef]
- Aeron, A.; Khare, E.; Arora, N.K.; Maheshwari, D.K. Practical use of CMC-amended rhizobial inoculant for Mucuna pruriens cultivation to enhance the growth and protection against Macrophomina phaseolina. J. Gen. Appl. Microbiol. 2012, 58, 121–127. [Google Scholar] [CrossRef] [PubMed]
- Abdelrahim, K.A.; Ramaswamy, H.S.; Doyon, G.; Toupin, C. Effects of concentration and temperature on carboxymethylcellulose rheology. Int. J. Food Sci. Technol. 1994, 29, 243–253. [Google Scholar] [CrossRef]
- Niu, F.; Gu, F.; Zhao, M.; Gao, Y.; Tu, W.; Kou, M.; Pan, W. Aggregation and growth mechanism of ovalbumin and sodium carboxymethylcellulose colloidal particles under thermal induction. Biomacromolecules 2023, 24, 1532–1543. [Google Scholar] [CrossRef] [PubMed]
- BeMiller, J.N. Hydrocolloids. In Gluten-Free Cereal Products and Beverages; Arendt, E.K., Bello, F.D., Eds.; Academic Press: Cambridge, MA, USA, 2008; pp. 203–215. [Google Scholar] [CrossRef]
- Dal Bello, G.M.; Mónaco, C.I.; Simón, M.R. Biological control of seedling blight of wheat caused by Fusarium graminearum with beneficial rhizosphere microorganisms. World J. Microbiol. Biotechnol. 2002, 18, 627–636. [Google Scholar] [CrossRef]
- Crittenden, R.; Laitila, A.; Forssell, P.; Matto, J.; Saarela, M.; Mattila-Sandholm, T.; Myllarinen, P. Adhesion of bifidobacteria to granular starch and its implications in probiotic technologies. Appl. Environ. Microbiol. 2001, 67, 3469–3475. [Google Scholar] [CrossRef]
- Bueno, P.A.A.; Balestri, E.L.; Rosiello, R.D.A.V.F.; Silva, C.C.; Gualdi, B.L.; Oliveira, V.M.A.T.; Cristófoli, J.B.; Sekine, E.S.; Bueno, R.O. Use of starch manufacturer residue in the production of inoculating biofertilizer. Rev. Eletrôn. Gest. Educ. Tecnol. Ambient. 2019, 23, 13. [Google Scholar] [CrossRef]
- Hungria, M.; Loureiro, M.F.; Mendes, I.C.; Campo, R.J.; Graham, P.H. Inoculant preparation, production and application. In Nitrogen Fixation in Agriculture, Forestry, Ecology, and the Environment; Werner, D., Newton, W.E., Eds.; Springer: Dordrecht, The Netherlands, 2005; pp. 223–253. [Google Scholar]
- Bashan, Y.; Hernandez, J.P.; Leyva, L.A.; Bacilio, M. Alginate microbeads as inoculant carriers for plant growth-promoting bacteria. Biol. Fertil. Soils 2002, 35, 359–368. [Google Scholar] [CrossRef]
- Bailey, B.A.; Hebbar, K.P.; Strem, M.; Lumsden, R.D. Formulations of Fusarium oxysporum f.sp. erythroxyli for biocontrol of Erythroxylum coca var. coca. Weed Sci. 1998, 46, 682–689. [Google Scholar] [CrossRef]
- He, X.; He, F.; Hang, J.; Li, H.; Chen, Y.; Wei, P.; Chen, K.; Li, Y.; OuYang, P. Enhanced production of exopolysaccharides using industrial grade starch as sole carbon source. Bioproc. Biosyst. Eng. 2018, 41, 811–817. [Google Scholar] [CrossRef]
- Beauregard, P.B.; Chai, Y.; Vlamakis, H.; Losick, R.; Kolter, R. Bacillus subtilis biofilm induction by plant polysaccharides. Proc. Natl. Acad. Sci. USA 2013, 110, E1621–E1630. [Google Scholar] [CrossRef]
- Lertsarawut, P.; Rattanawongwiboon, T.; Tangthong, T.; Laksee, S.; Kwamman, T.; Phuttharak, B.; Romruensukharom, P.; Suwanmala, P.; Hemvichian, K. Starch-based super water absorbent: A promising and sustainable way to increase survival rate of trees planted in arid areas. Polymers 2021, 13, 1314. [Google Scholar] [CrossRef] [PubMed]
- Argüelles, J.C. Physiological roles of trehalose in bacteria and yeasts: A comparative analysis. Arch. Microbiol. 2000, 174, 217–224. [Google Scholar] [CrossRef] [PubMed]
- Domínguez-Ferreras, A.; Soto, M.J.; Pérez-Arnedo, R.; Olivares, J.; Sanjuán, J. Importance of trehalose biosynthesis for Sinorhizobium meliloti osmotolerance and nodulation of alfalfa roots. J. Bacteriol. 2009, 191, 7490–7499. [Google Scholar] [CrossRef] [PubMed]
- Moussaid, S.; Domínguez-Ferreras, A.; Muñoz, S.; Aurag, J.; Berraho, E.B.; Sanjuán, J. Increased trehalose biosynthesis improves Mesorhizobium ciceri growth and symbiosis establishment in saline conditions. Symbiosis 2015, 67, 103–111. [Google Scholar] [CrossRef]
- Sugawara, M.; Cytryn, E.J.; Sadowsky, M.J. Functional role of Bradyrhizobium japonicum trehalose biosynthesis and metabolism genes during physiological stress and nodulation. Appl. Environ. Microbiol. 2010, 76, 1071–1081. [Google Scholar] [CrossRef]
- Cytryn, E.J.; Sangurdekar, D.P.; Streeter, J.G.; Franck, W.L.; Chang, W.S.; Stacey, G.; Emerich, D.W.; Joshi, T.; Xu, D.; Sadowsky, M.J. Transcriptional and physiological responses of Bradyrhizobium japonicum to desiccation-induced stress. J. Bacteriol. 2007, 189, 6751–6762. [Google Scholar] [CrossRef]
- Streeter, J.G. Effect of trehalose on survival of Bradyrhizobium japonicum during desiccation. J. Appl. Microbiol. 2003, 95, 484–491. [Google Scholar] [CrossRef]
- Suárez, R.; Wong, A.; Ramírez, M.; Barraza, A.; Orozco, M.D.C.; Cevallos, M.A.; Lara, M.; Hernández, G.; Iturriaga, G. Improvement of drought tolerance and grain yield in common bean by overexpressing trehalose-6-phosphate synthase in rhizobia. Mol. Plant Microbe Interact. 2008, 21, 958–966. [Google Scholar] [CrossRef]
- Orozco-Mosqueda, M.D.C.; Duan, J.; DiBernardo, M.; Zetter, E.; Campos-García, J.; Glick, B.R.; Santoyo, G. The production of ACC deaminase and trehalose by the plant growth promoting bacterium Pseudomonas sp. UW4 synergistically protect tomato plants against salt stress. Front. Microbiol. 2019, 10, 1392. [Google Scholar] [CrossRef]
- Streeter, J.G. Accumulation of alpha, alpha-trehalose by Rhizobium bacteria and bacteroids. J. Bacteriol. 1985, 164, 78–84. [Google Scholar] [CrossRef]
- Kandror, O.; DeLeon, A.; Goldberg, A.L. Trehalose synthesis is induced upon exposure of Escherichia coli to cold and is essential for viability at low temperatures. Proc. Natl. Acad. Sci. USA 2002, 99, 9727–9732. [Google Scholar] [CrossRef] [PubMed]
- Cheng, Z.; Park, E.; Glick, B.R. 1-Aminocyclopropane-1-carboxylate deaminase from Pseudomonas putida UW4 facilitates the growth of canola in the presence of salt. Can. J. Microbiol. 2007, 53, 912–918. [Google Scholar] [CrossRef] [PubMed]
- di Gennaro, M.; Della Sala, F.; Vinale, F.; Borzacchiello, A. Design of carboxymethylcellulose/poloxamer-based bioformulation embedding Trichoderma afroharzianum for agricultural applications. Langmuir 2024, 40, 12159–12166. [Google Scholar] [CrossRef] [PubMed]
- Sanz, T.; Fernández, M.A.; Salvador, A.; Muñoz, J.; Fiszman, S.M. Thermogelation properties of methyl-cellulose (MC) and their effect on a batter formula. Food Hydrocoll. 2005, 19, 141–147. [Google Scholar] [CrossRef]
- Lauer, N. Elevated root zone pH and NaCl leads to decreased foliar nitrogen, chlorophyll, and physiological performance in trembling aspen (Populus tremuloides), green alder (Alnus alnobetula), tamarack (Larix laricina), and white spruce (Picea glauca). Trees 2023, 37, 1041–1054. [Google Scholar] [CrossRef]
- Naz, M.; Dai, Z.; Hussain, S.; Tariq, M.; Danish, S.; Khan, I.U.; Qi, S.; Du, D. The soil pH and heavy metals revealed their impact on soil microbial community. J. Environ. Manag. 2022, 321, 115770. [Google Scholar] [CrossRef]
- Neina, D. The role of soil pH in plant nutrition and soil remediation. Appl. Environ. Soil Sci. 2019, 2019, 5794869. [Google Scholar] [CrossRef]
- Rivera, D.; Obando, M.; Barbosa, H.; Rojas Tapias, D.; Bonilla Buitrago, R. Evaluation of polymers for the liquid rhizobial formulation and their influence in the Rhizobium-Cowpea interaction. Univ. Sci. 2014, 19, 265–275. [Google Scholar] [CrossRef]
- Rumbiak, J.E.R.; Hilal, S. Increasing shelf life of rhizobacteria formula with alginate in encapsulation during storage. In IOP Conference Series: Earth and Environmental Science; IOP Publishing: Bristol, UK, 2021; p. 012025. [Google Scholar] [CrossRef]
- Turenne, C.Y.; Snyder, J.W.; Alexander, D.C. Bacillus and other aerobic endospore-forming bacteria. In Manual of Clinical Microbiology; Wiley: Hoboken, NJ, USA, 2015; pp. 441–461. [Google Scholar] [CrossRef]
Disclaimer/Publisher’s Note: The statements, opinions and data contained in all publications are solely those of the individual author(s) and contributor(s) and not of MDPI and/or the editor(s). MDPI and/or the editor(s) disclaim responsibility for any injury to people or property resulting from any ideas, methods, instructions or products referred to in the content. |
© 2025 by the authors. Licensee MDPI, Basel, Switzerland. This article is an open access article distributed under the terms and conditions of the Creative Commons Attribution (CC BY) license (https://creativecommons.org/licenses/by/4.0/).